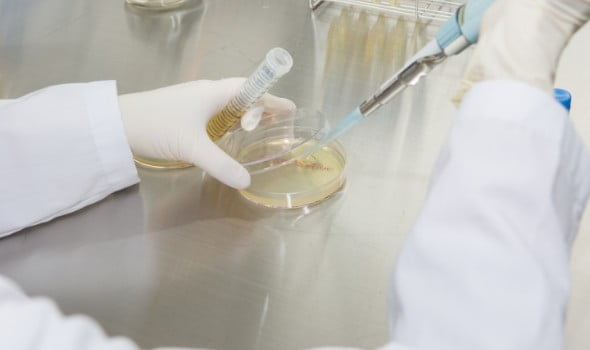
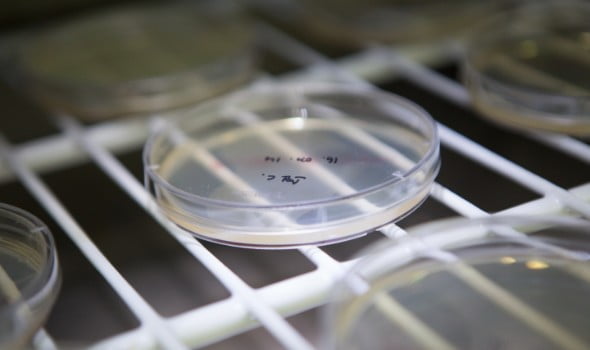

Business
생산 및 제조
ISO·CGMP 인증을 갖춘 첨단 시설에서 원료 입고부터 생산, 품질관리, 패키징까지 모든 과정을 철저하게 관리합니다.
자동화된 설비와 표준화된 공정을 기반으로 고객이 원하는 제품을 안정적으로 생산합니다.
1. 생산 및 제조 (Production & Manufacturing)
원자재 보관실에는 정해진 품질 검사를 통과한 원자재만 적절한 라벨과 함께 보관됩니다.
또한 제조 과정에서 사용되는 원료들은 정확하게 계량되어 생산 라인에 투입되며, 이를 통해 우수한 품질의 화장품을 안정적으로 생산할 수 있습니다.
2. 포장 및 패키징 (Packaging)
입고된 자재는 에어클리너나 세척기를 통해 철저히 세정한 후 제품 유형에 맞는 충전기를 사용하여 내용물을 채웁니다.
충전된 제품은 라벨링 및 마킹 과정을 거쳐 식별 가능하게 처리되며 마지막으로 단일 박스에 포장하여 안전하고 효율적으로 출하 준비를 마칩니다.
3. 품질관리 (Quality Control System)
당사는 국제 표준에 부합하는 과학적이고 체계적인 품질 관리 시스템을 운영합니다.
원자재와 부자재, 반제품, 완제품 전 과정에 걸쳐 철저한 검증 절차를 통해 안전하고 신뢰할 수 있는 화장품을 공급합니다.